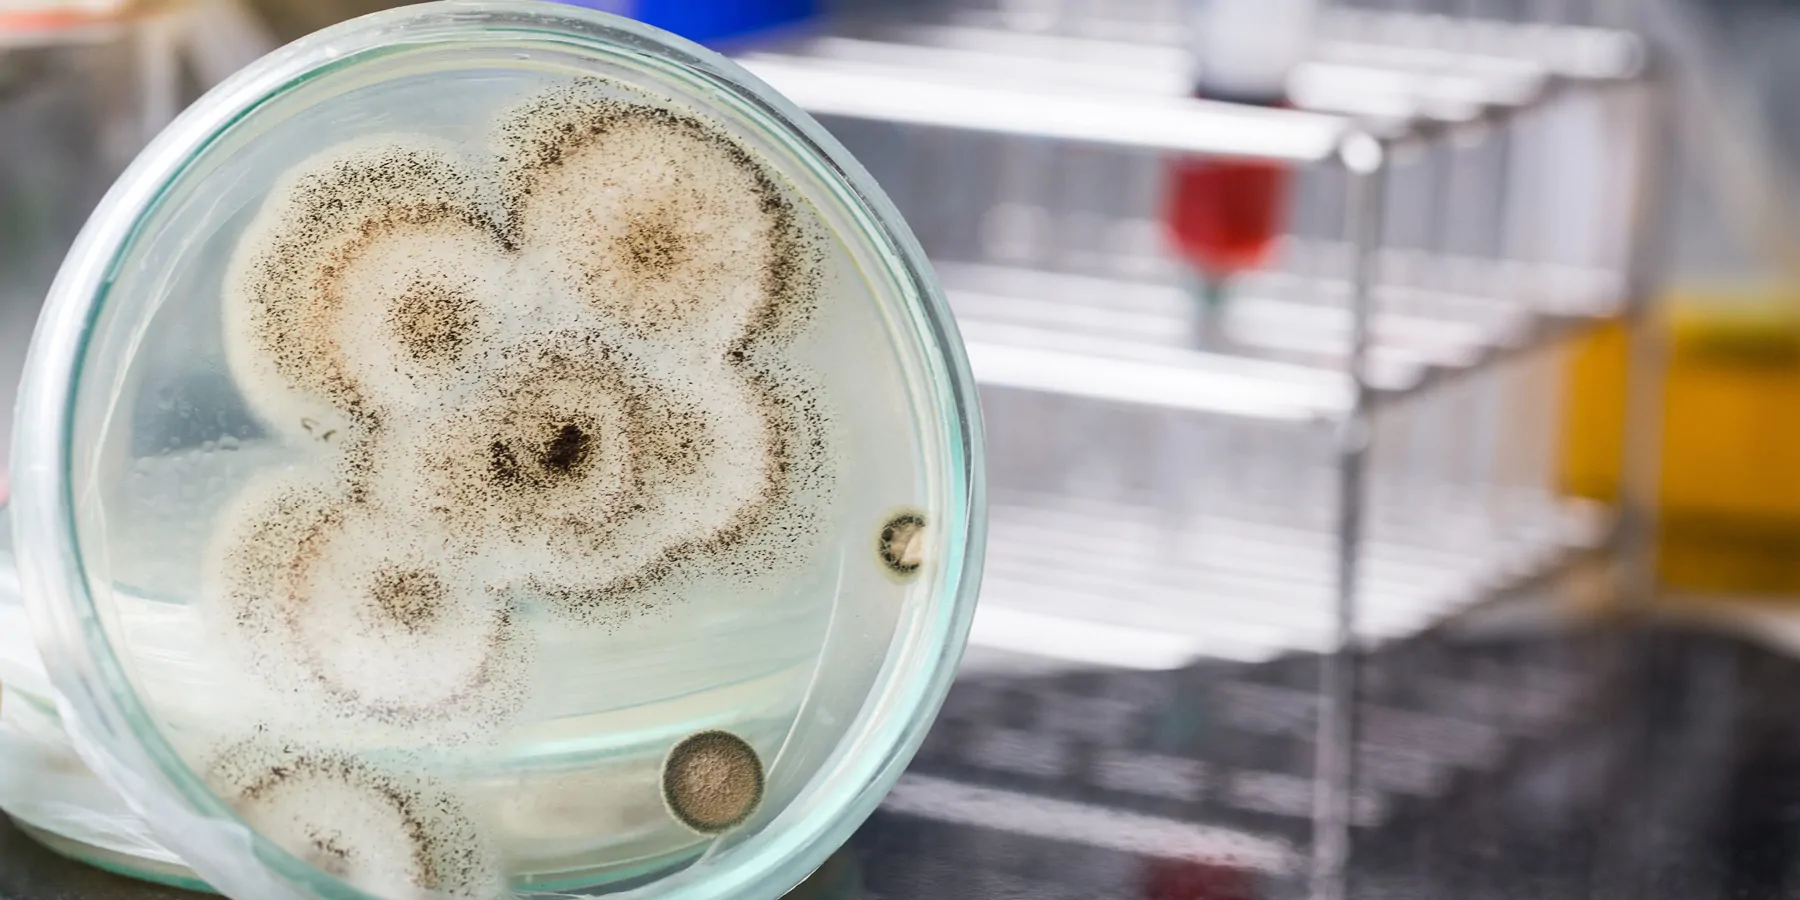
A gloved hand holds a petridish with fungal colonies

Antimicrobial-Resistant C. auris Rampant in Healthcare Facilities
Clinical cases screened for C. auris infection spiked from 44 percent in 2019 to 95 percent in 2021
Candida auris (C. auris), an emerging fungus considered an urgent antimicrobial resistance (AMR) threat, spread at an alarming rate in US health care facilities in 2020–2021, according to data from the Centers for Disease Control and Prevention (CDC) published in the Annals of Internal Medicine. Equally concerning in 2021 was a tripling of the number of cases that were resistant to echinocandins, the antifungal medicine most recommended for treatment of C. auris infections.
In general, C. auris is not a threat to healthy people. People who are very sick, have invasive medical devices, or have long or frequent stays in health care facilities are at increased risk for acquiring C. auris. The CDC has deemed C. auris as an urgent AMR threat, because it is often resistant to multiple antifungal drugs, spreads easily in health care facilities, and can cause severe infections with high death rates.
“The rapid rise and geographic spread of cases are concerning and emphasize the need for continued surveillance, expanded lab capacity, quicker diagnostic tests, and adherence to proven infection prevention and control,” said Meghan Lyman, MD, CDC epidemiologist and lead author of the paper.
As further explained in the article, C. auris has spread in the US since it was first reported in 2016, with a total of 3,270 clinical cases (in which infection is present) and 7,413 screening cases (in which the fungus is detected but not causing an infection) reported through December 31, 2021.
Clinical cases have increased each year since 2016, with the most rapid rise occurring during 2020–2021. The CDC continues to see an increase in case counts for 2022. During 2019–2021, 17 states identified their first C. auris case ever. Nationwide, clinical cases rose from 476 in 2019 to 1,471 in 2021. Screening cases tripled from 2020 to 2021, for a total of 4,041.
Screening is important to prevent the spread by identifying patients carrying the fungus so that infection prevention controls can be used.
C. auris case counts have increased for many reasons, including poor general infection prevention and control (IPC) practices in health care facilities. Case counts may also have increased because of enhanced efforts to detect cases, including increased colonization screening or people testing to see if someone has the fungus somewhere on their body but does not have an infection or symptoms of infection.
The timing of this increase and findings from public health investigations suggest C. auris spread may have worsened due to strain on health care and public health systems during the COVID-19 pandemic. The CDC’s Antimicrobial Resistance Laboratory Network, which provides nationwide lab capacity to rapidly detect antimicrobial resistance and inform local responses to prevent the spread and protect people, provided some of the data for this report.
The CDC worked to significantly strengthen laboratory capacity, including in state, territorial, and local health departments, through supplemental funding supported by the American Rescue Plan Act. These efforts include increasing susceptibility testing capacity for C. auris from seven Regional Labs to more than 26 labs nationwide.
The CDC continues to work with state, local, and territorial health departments and other partners to address this emerging threat to public health.
- This press release was originally published on the Centers for Disease Control and Prevention website